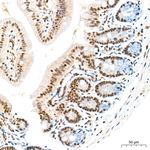
HEXIM1 Antibody in Immunohistochemistry (Paraffin) (IHC (P))

Search
Invitrogen
HEXIM1 Recombinant Rabbit Monoclonal Antibody (3H9F2)
{{$productOrderCtrl.translations['antibody.pdp.commerceCard.promotion.promotions']}}
{{$productOrderCtrl.translations['antibody.pdp.commerceCard.promotion.viewpromo']}}
{{$productOrderCtrl.translations['antibody.pdp.commerceCard.promotion.promocode']}}: {{promo.promoCode}} {{promo.promoTitle}} {{promo.promoDescription}}. {{$productOrderCtrl.translations['antibody.pdp.commerceCard.promotion.learnmore']}}
图: 1 / 12
HEXIM1 Antibody (MA569262) in ICC/IF

Please note: We are reviewing Western blot images included in the antibody testing data in our catalog, including those provided by third parties. Unless expressly labeled or annotated as “raw-unedited”, Western blot images included in the antibody testing data in our catalog may have been edited, optimized or otherwise adjusted for presentation.
产品信息
MA569262
种属反应
宿主/亚型
Expression System
分类
类型
克隆号
抗原
偶联物
形式
浓度
规格
纯化类型
保存液
内含物
保存条件
运输条件
靶标信息
The protein encoded by this gene is a member of the RecQ DNA helicase family. DNA helicases are enzymes involved in various types of DNA repair, including mismatch repair, nucleotide excision repair and direct repair. Some members of this family are associated with genetic disorders with predisposition to malignancy and chromosomal instability. The biological function of this helicase has not yet been determined. Two alternatively spliced transcripts, which encode the same isoform but differ in their 5' and 3' UTRs, have been described.
仅用于科研。不用于诊断过程。未经明确授权不得转售。
篇参考文献 (0)
生物信息学
蛋白别名: Cardiac lineage protein 1; Estrogen down-regulated gene 1 protein; FLJ13562; Hexamethylene bis-acetamide-inducible protein 1; HGNC:24953; Menage a quatre protein 1; Protein HEXIM1
基因别名: 7330426E13Rik; CLP-1; CLP1; EDG1; HEXIM1; HIS1; MAQ1
UniProt ID: (Mouse) Q8R409, (Rat) Q5M9G1
Entrez Gene ID: (Mouse) 192231, (Rat) 498008



